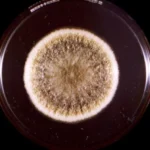

Мифы о космосе: 5 заблуждений о жизни человека на орбите
Взрывающиеся тела, путешествия во времени и ошеломляющие астероиды, большие как высотные здания — это изобилует воображаемыми мифами о наших путешествиях в космос.
МИФ 1: «КОСМОНАВТЫ НЕ ПОДВЕРЖЕНЫ ЗЕМНОМУ ПРИТЯЖЕНИЮ»
На записях с Международной космической станции (МКС) мы видим, как астронавты парят вокруг друг друга, хватаясь за фрукты и другие мелкие предметы, свободно плавающие в воздухе.
Это, пожалуй, одна из причин, почему самый большой миф о людях в космосе все еще застрял: что космонавты не подвержены влиянию гравитации Земли. Тем не менее астронавты испытывают до 90 процентов той же силы тяжести, что и мы на Земле.
Вместо этого объяснение их воздушной акробатики заключается в постоянном свободном падении, когда они находятся на орбите. Хотя космическая станция находится примерно в 400 километрах над поверхностью Земли, она постоянно движется вниз к планете — она находится в свободном падении.
Высокая скорость космической станции — 28 000 километров в час, а искривление Земли означает, что она постоянно движется по своей орбите.
Астронавты летают быстрее, чем могут упасть
Первый
Земное притяжение тянет МКС — и астронавтов, которые там находятся на борту — к Земле.

Второй
Космическая станция и все в ней одновременно движутся со скоростью 28 000 километров в час.

Третий
Объединенный эффект двух сил — это длинный круговой случай, который никогда не достигает земли.

В принципе, можно сказать, что он падает с той же скоростью, что и кривизна земли, как и пушечное ядро, которое отталкивается от вершины горы с достаточной скоростью.
Это также относится к экипажу внутри космической станции, который не движется по отношению к кораблю и, следовательно, не ударяется об пол.
Несмотря на то, что гравитация постепенно отступает по мере нашего выхода в космос, нигде во Вселенной она не исчезает полностью.
Миф о космонавтах и гравитации: ЛОЖЬ
МИФ 2: «ТОЛЬКО ТРИ ЧЕЛОВЕКА ПОГИБЛИ В КОСМОСЕ»
Открытый вентиляционный клапан имел катастрофические последствия для трех космонавтов, которые считаются единственными людьми, погибшими в космосе.
30 июня 1971 года космическая капсула «Союз-11» совершила совершенную посадку.
После 23 дней пребывания в космосе космонавты Георгий Добровольский, Владислав Волков и Виктор Пацаев завершили успешную экспедицию на борту первой в мире космической станции «Салют-1». Когда капсула с космонавтами была открыты на земле, к своему ужасу обнаружили всех трех космонавтов мертвыми в своих креслах.

Оказывается, вентиляционный клапан открылся на 168 километров над земной поверхностью, и что низкое космическое давление стоило жизни трем людям.
С тех пор другие несчастные случаи со смертельным исходом вошли в самую мрачную главу космической истории, но катастрофа «Союз» до сих пор считается единственной, произошедшей в космосе.
Хотя граница между атмосферой Земли и космическим пространством все еще активно обсуждается, международные организации проводят навигацию по так называемой линии Кармана, расположенной в термосфере на высоте 100 км над уровнем моря и названной в честь физика Теодора фон Кармана.
НАСА предпочло установить ограничение в 80 километров над Землей, но это не меняет число убитых людей.
Миф о том, что только три человека погибли в космосе: ИСТИНА
МИФ 3: «ВЫ СТАНОВИТЕСЬ МОЛОЖЕ, ПУТЕШЕСТВУЯ В КОСМОСЕ»
В научно-фантастических приключениях есть много историй о героических астронавтах, которые совершают сотни лет космических путешествий, не постарев, и которые в некоторых случаях возвращаются на поверхность земли значительно моложе. Однако астронавты не становятся моложе, путешествуя в космосе — они только стареют медленнее, чем люди на Земле.
Объяснение должно быть в теории относительности Эйнштейна, которая доказывает, что время зависит от скорости движения объекта: чем быстрее он движется, тем медленнее идет время.

Однако космический корабль должен быть близок к скорости света, прежде чем разница во времени будет заметна и видна.
Например, астронавты Международной космической станции, МКС, стареют всего на несколько миллисекунд медленнее, чем мы здесь, на Земле, хотя они путешествуют на 28 000 километров в час.
Миф о том, что вы становитесь моложе от путешествий в космосе: ЛОЖЬ
МИФ 4: «ОПАСНО ПУТЕШЕСТВОВАТЬ ЧЕРЕЗ ПОЯС АСТЕРОИДОВ»
Пояс астероидов часто называют опасной зоной с миллионами гигантских камней, собранных в кольцо. Но в действительности почти невозможно статистически столкнуться с каменистыми валунами.
С миллионами гигантских камней в одной области пояс астероидов выглядит как опасная полоса препятствий, где астронавты могут погибнуть.
Несмотря на большое количество астероидов, это все еще пустынный ландшафт, в котором встретились бы астронавты, которые прибыли на отрезок между Марсом и Юпитером, протянувшийся на несколько миллионов километров. По оценкам НАСА, среднее расстояние между астероидами в поясе составляет 966 000 километров — эквивалент более чем в 24 раза больше окружности Земли.
Это означает, что риск столкновения с астероидом составляет один на миллиард.
Эта теория подтверждается многочисленными экспедициями НАСА к планетам во внешней части солнечной системы, где все машины без проблем пролетали через эту область, включая экспедиции Вояджер, отправленные в 1977 году для исследования Юпитера и Сатурна и все еще функционирующие в межзвездном пространстве.

НАСА также провело три экспедиции, где пояс был конечной целью.
В 2018 году НАСА, например, завершило свою экспедицию Dawn, в которой космический зонд исследовал два крупнейших небесных тела планету Цереру и астероид Весту, в течение одиннадцати лет без каких-либо столкновений.
Миф о том, что путешествовать через пояс астероидов опасно: ЛОЖЬ
МИФ 5: «ВАКУУМ ПРОСТРАНСТВА ЗАСТАВЛЯЕТ ВАШЕ ТЕЛО ВЗРЫВАТЬСЯ»
Астронавт в принципе может прожить несколько минут без своего скафандра. Но за это время вы получаете лучевую болезнь и органы отключаются один за другим.
Налитые кровью глаза вырвались из черепа в момент снятия космического шлема.
В течение нескольких секунд голова раздувается до неузнаваемости, прежде чем она окончательно взрывается в кровавую массу.
Голливудские фильмы показали, что человеческое тело сильно пострадает без защитной атмосферы Земли — и это не преувеличение.
Немногие молекулы воздуха в космосе делают давление низким — в основном настолько низким, что образуется полная пустота: вакуум.
Но несмотря на то, что отсутствие давления одновременно расширяет тело до двойных размеров и выдавливает органы через отверстия тела, тело не взрывается в классическом смысле.
На практике астронавты могут выжить от 90 секунд до трех минут, прежде чем они умрут.
Однако без земной атмосферы и магнитного поля астронавт в считанные секунды сгорает от ультрафиолетовых лучей и получает лучевую болезнь от так называемых гамма-лучей, самого мощного электромагнитного излучения, которое существует.
Миф о том, что тело может взорваться в пространстве: ложь